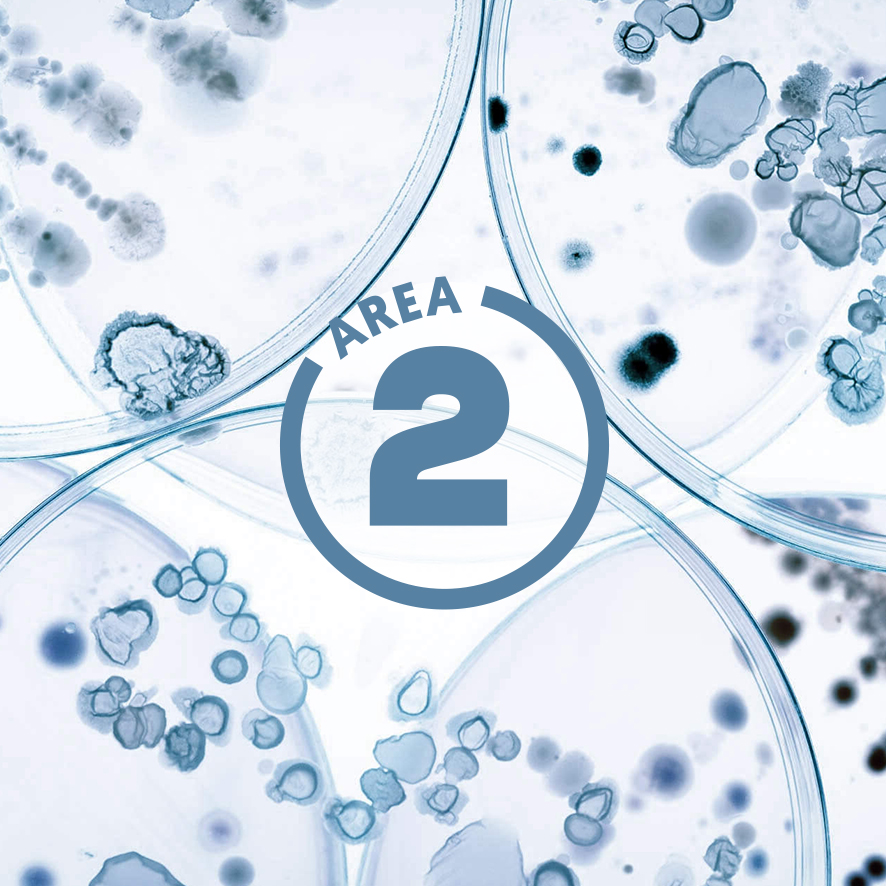
ffoqsi_area-symbol2_blau

FFoQSI's AREAS OF EXPERTISE
DIGITAL
TRANSFORMATION
OF FOOD SUPPLY CHAINS
Digitale Transformationen
der Lebensmittel-
Versorgungsketten
Der Bereich 4 von FFoQSI zielt darauf ab, die Anpassungsfähigkeit von Lebensmittelsystemen zu verbessern, um auf Störungen zu reagieren, potenzielle Schäden zu mindern, Chancen zu nutzen und die Folgen des Wandels zu bewältigen.